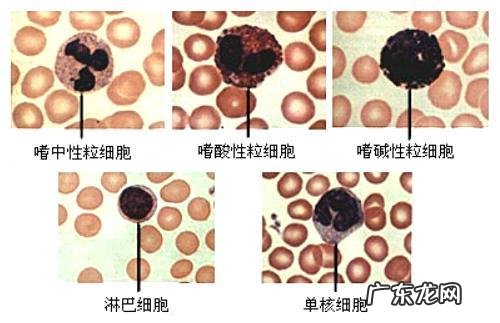
血常规检查主要查哪几项?

红细胞数量(RBC)、血红蛋白含量(Hb);血小板数量(PLT) 。

文章插图
各项指标所代表的意义是:
正常值为4-10×10^9/L,新生儿1.5-2.0×10^9/L 。白细胞数量升高常见于炎性感染、出血、中毒、白血病等,特别是中性粒细胞比例增高多提示有细菌感染、淋巴细胞比例增高多见于百日咳、病毒感染、寄生虫病;
白细胞计数减少常见于病毒感染、伤寒、副伤寒、疟疾、严重败血症、药物和射线所致的白细胞减少等;嗜酸细胞比例升高常提示寄生虫感染和过敏反应 。
文章插图
白细胞大家族
那么剩下的指标都算是白细胞大家族的成员咯 。
白细胞(WBC)的增加或减少主要受到中性粒细胞的影响,其次是淋巴细胞 。
白细胞各种组分也保持相对稳定的比例,例如中性粒细胞正常情况下占所有白细胞的50–70% 。
大部分科室的医生主要用WBC来分析感染性疾病,不同类型的白细胞升高常常对应不同类型的感染,因为WBC里的各种成分都有抵御外来入侵的作用 。
一般情况下,
细菌感染会让前线兵种中性粒细胞升高;
但是病毒感染能绕过前线兵种,直接挑战炮兵团淋巴细胞;
单核细胞算是特种兵吧,只是在面对疟疾、结核等几个敌人时才出马;
嗜酸性粒细胞是一个脾气火爆的战士,对于寄生虫感染常常积极升高应战,但是它有时候也会对一些本来无关紧要的刺激过度亢奋,引起过敏;
至于嗜碱性粒细胞,他政治立场不坚定,常常挑拨离间,它的升高常常见于自身免疫病攻击自身 。

文章插图
其中,中性粒细胞比例(NEUT)(单位:%)是我们重点看的指标,正常值:50-70%
大于正常值:见于急性化脓性细菌感染、粒细胞白血病、急性出血、严重组织损伤或血细胞破坏、败血症、心肌梗死、尿毒症、糖尿病酮症酸中毒及等;
小于正常值:见于伤寒、副伤寒、病毒性感染、疟疾、粒细胞缺乏症、化学药物中毒、X线和放射线照射、抗癌药物治疗、自身免疫性疾病和脾功能亢进等 。
淋巴细胞比值(LY)(单位:%)正常值:17-50%
大于正常值:百日咳,传染性单核细胞增多症,病毒感染,急性传染性淋巴细胞增多症,淋巴细胞性白血病;
小于正常值:免疫缺陷、长期化疗、X射线照射后 。
正常值是男4.0-5.50×10^12/L,女3.5-5.0×10^12/L,新生儿6.0-7.0×10^12/L 。严重脱水和缺氧可使红细胞计数升高,如肺原性心脏病,先天性心脏病,高山地区的居民,严重烧伤,休克等;小于正常值见于贫血、出血 。
血红蛋白浓度正常值是:男:120-160 g/L,女110-150 g/L,新生儿 170-200 g/L 。血红蛋白浓度减少临床可诊断为贫血 。

文章插图
正常值是男:100-300×10^9/L,女:100-300×10^9/L,新生儿100-300×10^9/L 。临床上血小板计数减少较血小板计数增高临床意义大,可见于原发性血小板减少性紫癜,药物过敏性血小板减少症,弥漫性血管内凝血,再生障碍性贫血,药物引起的骨髓抑制,脾功能亢进等 。
血常规检查包括更多,主要包括中性粒细胞、红细胞、血小板数量、血红蛋白含量、平均红细胞体积、平均红细胞含量、嗜酸性粒细胞数量、嗜酸性粒细胞比例、淋巴细胞数量、淋巴细胞比例、血小板体积血小板含量 。细菌感染,中性粒细胞和白细胞增多 。当病毒被感染时,淋巴细胞和淋巴细胞的比例增加 。当过敏发生时,嗜酸性粒细胞和嗜酸性粒细胞的比例会增加 。
- 流出的姨妈有血块是否暗示血瘀严重?
- o型血爸爸的孩子是什么血型?
- 有一个朋友好不容易怀孕,去检查医生说生化了,她还能再要吗?
- 澳大利亚科学家说高胆固醇和心脑血管疾病发病无关,真的如此吗?
- 降血糖的十种最佳食物
- 肾功能检查应该做哪些项目?
- 高血压能吃西瓜吗
- 流鼻血是什么原因?
- 恭喜EDG,再见777!EDG常规赛完美收官,厂长因0次登场将无缘季后赛,他真的不上场了吗?
- 男性生殖4项都检查什么?
特别声明:本站内容均来自网友提供或互联网,仅供参考,请勿用于商业和其他非法用途。如果侵犯了您的权益请与我们联系,我们将在24小时内删除。
